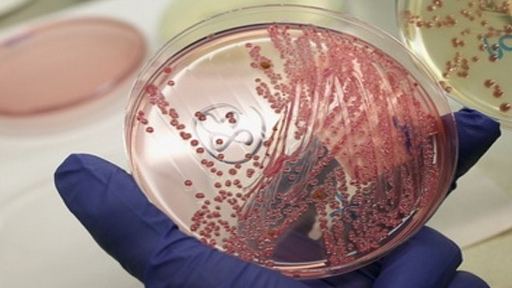
منظمة الصحة العالمية: تفشي بكتريا الليستريا في جنوب أفريقيا هو الأكبر

06 آذار 2018, 07:38
منظمة الصحة العالمية: تفشي بكتريا الليستريا في جنوب أفريقيا هو الأكبر
قالت منظمة الصحة العالمية إن تفشي بكتريا الليستريا في جنوب أفريقيا هو أكبر تفش مسجل في العالم إلى الآن. وأودى التفشي بحياة 180 شخصا منذ يناير كانون الثاني الماضي.
وقال بيتر إمبارك الذي يدير الشبكة الدولية للهيئات المسؤولة عن سلامة الأغذية بمنظمة الصحة العالمية لرويترز في رد أرسله عبر البريد الإلكتروني يوم الاثنين ”نعم هذا أكبر تفش لهذا الشكل الفتاك لبكتريا الليستريا على مستوى العالم إلى الآن“.